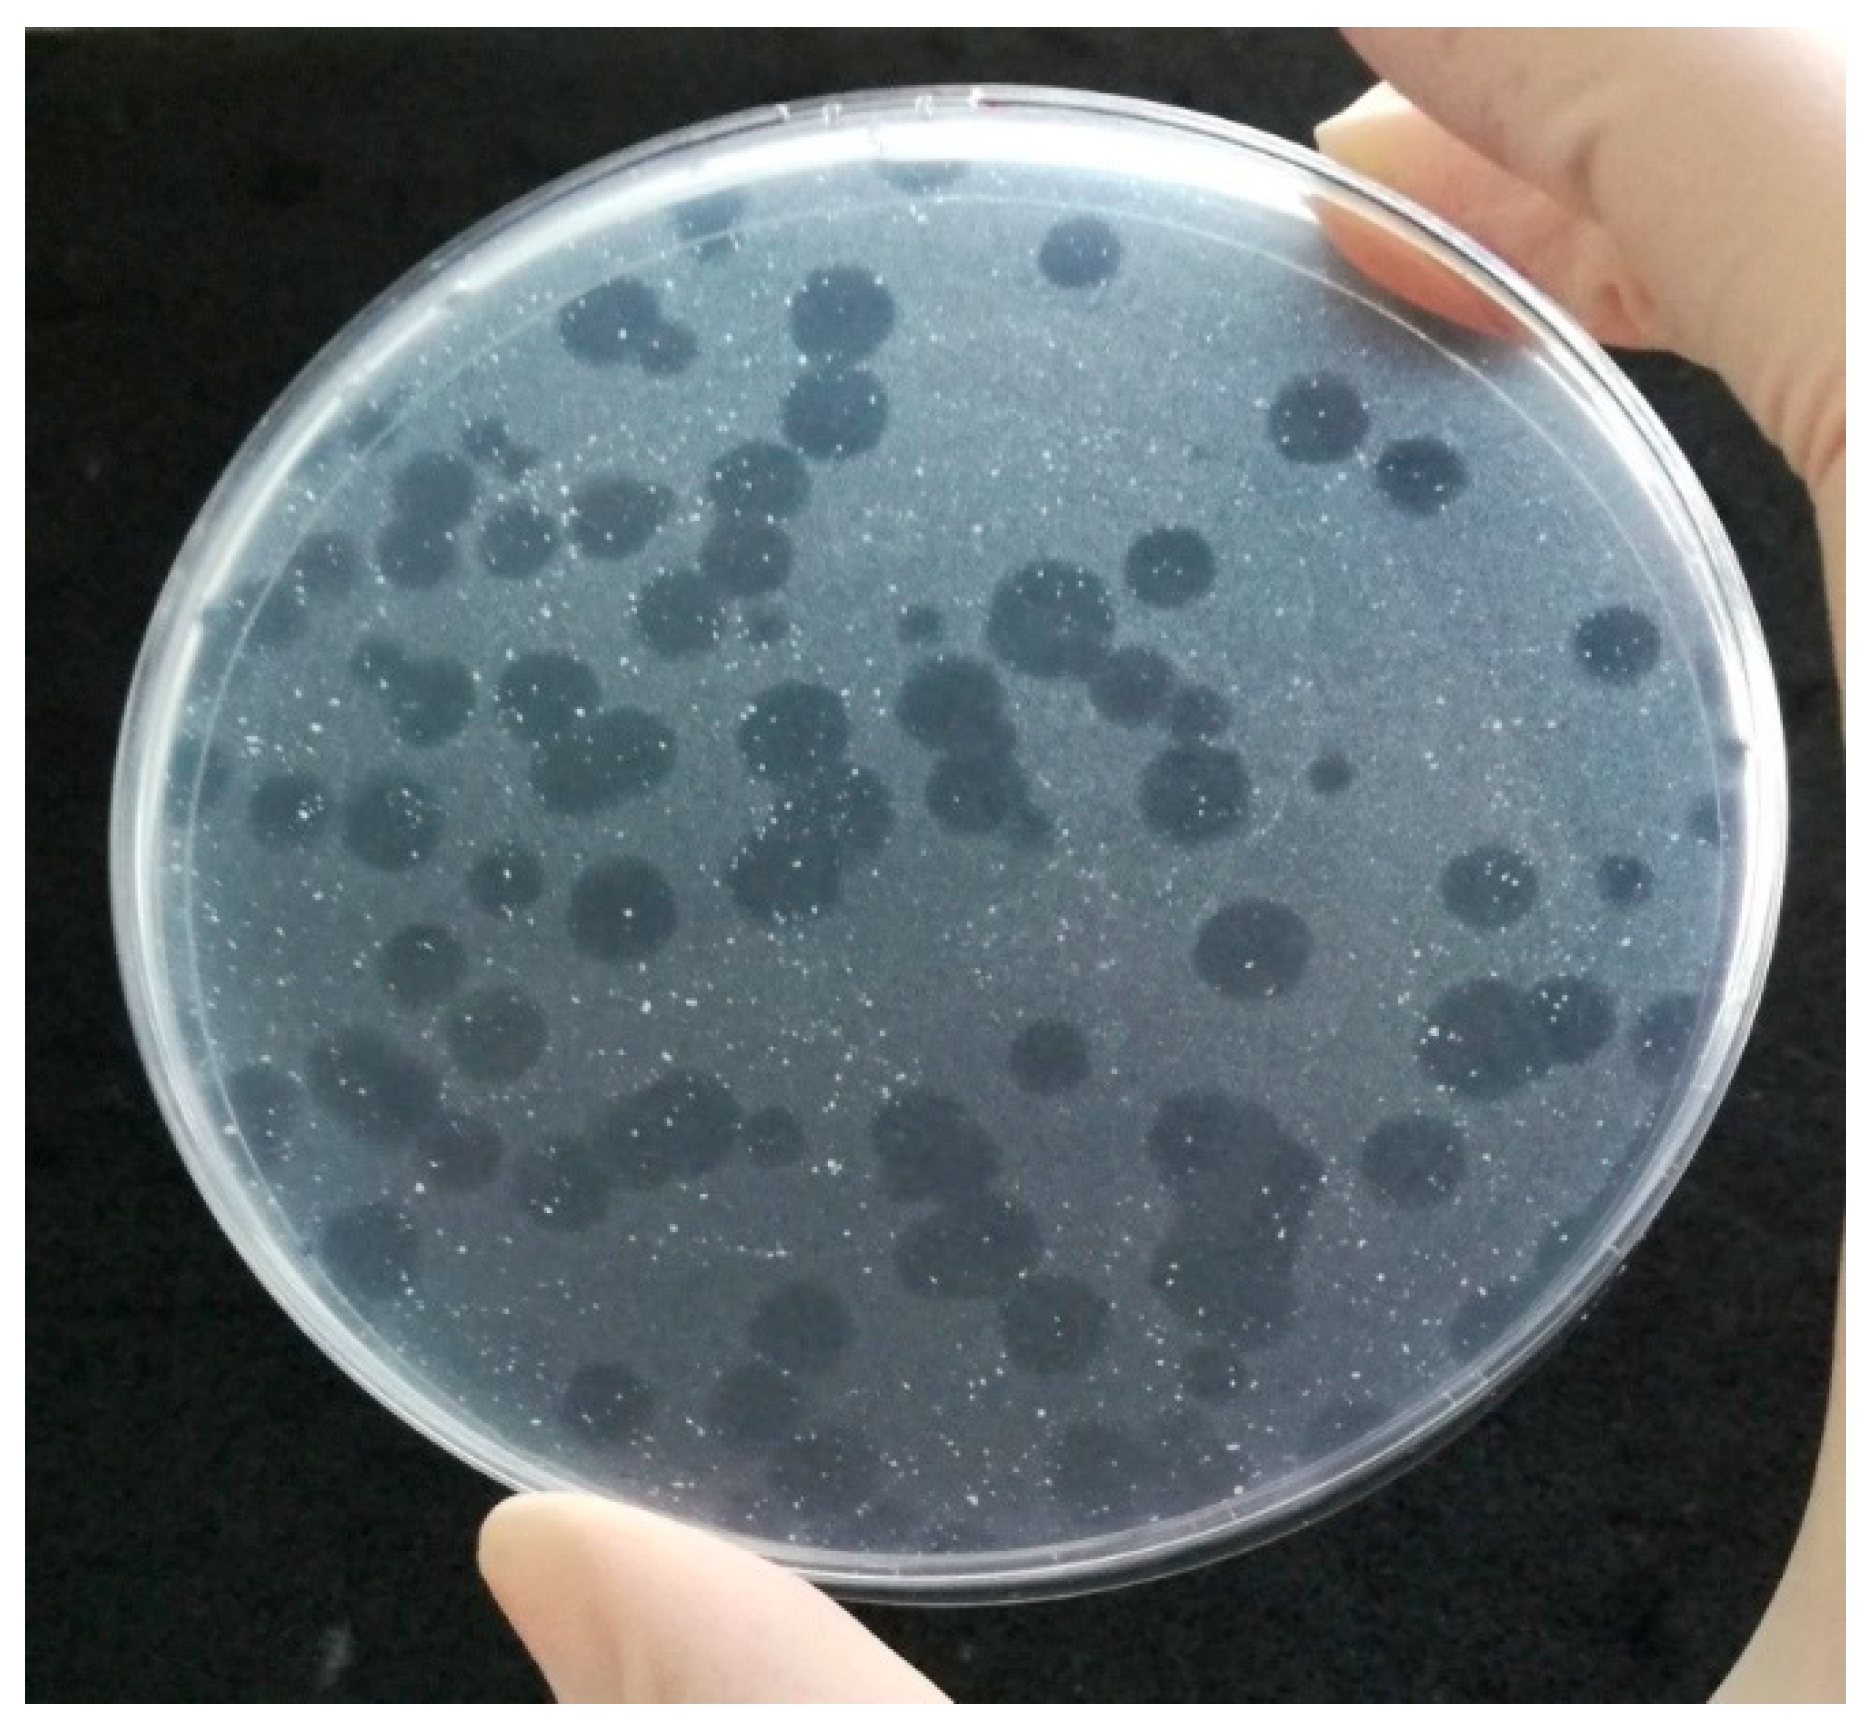

Phage Amplification Assay for Detection of Mycobacterial Infection: A Review
Abstract
1. Introduction
2. History and Principle of Phage Amplification Assay
3. Phage Amplification Assay for Detection of Mycobacteria Significant for Human Medicine
Detection of M. tuberculosis Complex Members in Human Clinical Samples by Phage Amplification Assay
4. Phage Amplification Assay for Detection of Mycobacteria Significant for Veterinary Medicine
Detection of M. avium subsp. paratuberculosis and M. bovis in Real Samples by Phage Amplification Assay
5. Combination of Phage Amplification Assay with Peptide-Mediated Magnetic Separation for Detection of Mycobacteria
Detection of M. avium subsp. paratuberculosis in Real Samples by Phage Amplification Assay in Combination with Peptide-Mediated Magnetic Separation
6. Conclusions
Author Contributions
Funding
Institutional Review Board Statement
Informed Consent Statement
Data Availability Statement
Conflicts of Interest
References
- Smith, R.L.; Schukken, Y.H.; Pradhan, A.K.; Smith, J.M.; Whitlock, R.H.; Van Kessel, J.S.; Wolfgang, D.R.; Grohn, Y.T. Environmental contamination with Mycobacterium avium subsp. paratuberculosis in endemically infected dairy herds. Prev. Vet. Med. 2011, 102, 1–9. [Google Scholar] [CrossRef] [PubMed]
- Nielsen, S.S.; Toft, N. A review of prevalences of paratuberculosis in farmed animals in Europe. Prev. Vet. Med. 2009, 88, 1–14. [Google Scholar] [CrossRef]
- Crawshaw, T. Wildlife hosts for Mycobacterium bovis. Vet. Rec. 2013, 173, 164–165. [Google Scholar] [CrossRef] [PubMed]
- World Health Organization. Global Tuberculosis Report 2020; World Health Organization: Geneva, Switzerland, 2020. [Google Scholar]
- Alcaide, F.; Gali, N.; Dominguez, J.; Berlanga, P.; Blanco, S.; Orus, P.; Martin, R. Usefulness of a new mycobacteriophage-based technique for rapid diagnosis of pulmonary tuberculosis. J. Clin. Microbiol. 2003, 41, 2867–2871. [Google Scholar] [CrossRef] [PubMed][Green Version]
- Kalantri, S.; Pai, M.; Pascopella, L.; Riley, L.; Reingold, A. Bacteriophage-based tests for the detection of Mycobacterium tuberculosis in clinical specimens: A systematic review and meta-analysis. BMC Infect. Dis. 2005, 5, 59. [Google Scholar] [CrossRef] [PubMed]
- Bonnet, M.; Gagnidze, L.; Varaine, F.; Ramsay, A.; Githui, W.; Guerin, P.J. Evaluation of FASTPlaqueTB™ to diagnose smear-negative tuberculosis in a peripheral clinic in Kenya. Int. J. Tuberc. Lung Dis. 2009, 13, 1112–1118. [Google Scholar] [PubMed]
- Prakash, S.; Katiyar, S.K.; Purwar, S.; Singh, J.P. Clinical evaluation of the mycobacteriophage-based assay in rapid detection of Mycobacterium tuberculosis in respiratory specimens. Indian J. Med. Microbiol. 2009, 27, 134–138. [Google Scholar] [CrossRef] [PubMed]
- Sharp, S.E.; Lemes, M.; Sierra, S.G.; Poniecka, A.; Poppiti, R.J., Jr. Lowenstein-Jensen media. No longer necessary for mycobacterial isolation. Am. J. Clin. Pathol. 2000, 113, 770–773. [Google Scholar] [CrossRef]
- Leitritz, L.; Schubert, S.; Bucherl, B.; Masch, A.; Heesemann, J.; Roggenkamp, A. Evaluation of BACTEC MGIT 960 AND BACTEC 460TB systems for recovery of mycobacteria from clinical specimens of a university hospital with low incidence of tuberculosis. J. Clin. Microbiol. 2001, 39, 3764–3767. [Google Scholar] [CrossRef]
- Shenai, S.; Rodrigues, C.; Mehta, A. Newer rapid diagnostic method for tuberculosis: A preliminary experience. Indian J. Tuberc. 2004, 51, 219–230. [Google Scholar]
- Albert, H.; Heydenrych, A.; Brookes, R.; Mole, R.J.; Harley, B.; Subotsky, E.; Henry, R.; Azevedo, V. Performance of a rapid phage-based test, FASTPlaqueTB™,to diagnose pulmonary tuberculosis from sputurn specimens in South Africa. Int. J. Tuberc. Lung Dis. 2002, 6, 529–537. [Google Scholar] [CrossRef]
- Muzaffar, R.; Batool, S.; Aziz, F.; Naqvi, A.; Rizvi, A. Evaluation of the FASTPlaqueTB assay for direct detection of Mycobacterium tuberculosis in sputum specimens. Int. J. Tuberc. Lung Dis. 2002, 6, 635–640. [Google Scholar] [PubMed]
- Marei, A.M.; El-Behedy, E.M.; Mohtady, H.A.; Afify, A.F. Evaluation of a rapid bacteriophage-based method for the detection of Mycobacterium tuberculosis in clinical samples. J. Med. Microbiol. 2003, 52, 331–335. [Google Scholar] [CrossRef][Green Version]
- Slana, I.; Kralik, P.; Kralova, A.; Pavlik, I. On-farm spread of Mycobacterium avium subsp. paratuberculosis in raw milk studied by IS900 and F57 competitive real time quantitative PCR and culture examination. Int. J. Food Microbiol. 2008, 128, 250–257. [Google Scholar] [CrossRef] [PubMed]
- Smartt, A.E.; Xu, T.T.; Jegier, P.; Carswell, J.J.; Blount, S.A.; Sayler, G.S.; Ripp, S. Pathogen detection using engineered bacteriophages. Anal. Bioanal. Chem. 2012, 402, 3127–3146. [Google Scholar] [CrossRef]
- Leite, F.L.; Stokes, K.D.; Robbe-Austerman, S.; Stabel, J.R. Comparison of fecal DNA extraction kits for the detection of Mycobacterium avium subsp. paratuberculosis by polymerase chain reaction. J. Vet. Diagn. Investig. 2013, 25, 27–34. [Google Scholar] [CrossRef]
- Olsen, I.; Sigurgardottir, G.; Djonne, B. Paratuberculosis with special reference to cattle. A review. Vet. Q. 2002, 24, 12–28. [Google Scholar] [CrossRef] [PubMed]
- Nielsen, S.S.; Toft, N. Age-specific characteristics of ELISA and fecal culture for purpose-specific testing for paratuberculosis. J. Dairy Sci. 2006, 89, 569–579. [Google Scholar] [CrossRef]
- Tiwari, R.P.; Hattikudur, N.S.; Bharmal, R.N.; Kartikeyan, S.; Deshmukh, N.M.; Bisen, P.S. Modern approaches to a rapid diagnosis of tuberculosis: Promises and challenges ahead. Tuberculosis 2007, 87, 193–201. [Google Scholar] [CrossRef] [PubMed]
- Stella, E.J.; De la Iglesia, A.I.; Morbidoni, H.R. Mycobacteriophages as versatile tools for genetic manipulation of mycobacteria and development of simple methods for diagnosis of mycobacterial diseases. Rev. Argent. Microbiol. 2009, 41, 45–55. [Google Scholar]
- Pai, M.; Kalantri, S.; Pascopella, L.; Riley, L.W.; Reingold, A.L. Bacteriophage-based assays for the rapid detection of rifampicin resistance in Mycobacterium tuberculosis: A meta-analysis. J. Infect. 2005, 51, 175–187. [Google Scholar] [CrossRef] [PubMed]
- Minion, J.; Pai, M. Bacteriophage assays for rifampicin resistance detection in Mycobacterium tuberculosis: Updated meta-analysis. Int. J. Tuberc. Lung Dis. 2010, 14, 941–951. [Google Scholar] [PubMed]
- Gardner, G.M.; Weiser, R.S. A bacteriophage for Mycobacterium smegmatis. Proc. Soc. Exp. Biol Med. 1947, 66, 205–206. [Google Scholar] [CrossRef] [PubMed]
- Tokunaga, T.; Sellers, M.I. Streptomycin induction of premature lysis of bacteriophage-infected mycobacteria. J. Bacteriol. 1965, 89, 537–538. [Google Scholar] [CrossRef]
- Hirsh, D.C.; Martin, L.D. Rapid detection of Salmonella spp. by using Felix-O1 bacteriophage and high-performance liquid chromatography. Appl. Environ. Microbiol. 1983, 45, 260–264. [Google Scholar] [CrossRef]
- Hirsh, D.C.; Martin, L.D. Detection of Salmonella spp. in milk by using Felix-O1 bacteriophage and high-pressure liquid chromatography. Appl. Environ. Microbiol. 1983, 46, 1243–1245. [Google Scholar] [CrossRef]
- Jassim, S.A.A.; Griffiths, M.W. Evaluation of a rapid microbial detection method via phage lytic amplification assay coupled with live/dead fluorochromic stains. Lett. Appl. Microbiol. 2007, 44, 673–678. [Google Scholar] [CrossRef]
- Sergueev, K.V.; He, Y.; Borschel, R.H.; Nikolich, M.P.; Filippov, A.A. Rapid and sensitive detection of Yersinia pestis using amplification of plague diagnostic bacteriophages monitored by real-time PCR. PLoS ONE 2010, 5, e11337. [Google Scholar] [CrossRef]
- Rees, J.C.; Barr, J.R. Detection of methicillin-resistant Staphylococcus aureus using phage amplification combined with matrix-assisted laser desorption/ionization mass spectrometry. Anal. Bioanal. Chem. 2017, 409, 1379–1386. [Google Scholar] [CrossRef]
- Pearson, R.E.; Jurgensen, S.; Sarkis, G.J.; Hatfull, G.F.; Jacobs, W.R. Construction of D29 shuttle phasmids and luciferase reporter phages for detection of mycobacteria. Gene 1996, 183, 129–136. [Google Scholar] [CrossRef]
- Goodridge, L.; Griffiths, M. Reporter bacteriophage assays as a means to detect foodborne pathogenic bacteria. Food Res. Int. 2002, 35, 863–870. [Google Scholar] [CrossRef]
- Bardarov, S.; Dou, H.; Eisenach, K.; Banaiee, N.; Ya, S.; Chan, J.; Jacobs, W.R.; Riska, P.F. Detection and drug-susceptibility testing of M. tuberculosis from sputum samples using luciferase reporter phage: Comparison with the Mycobacteria Growth Indicator Tube (MGIT) system. Diagn. Microbiol. Infec. Dis. 2003, 45, 53–61. [Google Scholar] [CrossRef]
- Piuri, M.; Jacobs, W.R.; Hatfull, G.F. Fluoromycobacteriophages for rapid, specific, and sensitive antibiotic susceptibility testing of Mycobacterium tuberculosis. PLoS ONE 2009, 4, e4870. [Google Scholar] [CrossRef] [PubMed]
- McNerney, R.; Wilson, S.M.; Sidhu, A.M.; Harley, V.S.; al Suwaidi, Z.; Nye, P.M.; Parish, T.; Stoker, N.G. Inactivation of mycobacteriophage D29 using ferrous ammonium sulphate as a tool for the detection of viable Mycobacterium smegmatis and M. tuberculosis. Res. Microbiol. 1998, 149, 487–495. [Google Scholar] [CrossRef]
- Froman, S.; Will, D.W.; Bogen, E. Bacteriophage active against virulent Mycobacterium tuberculosis I. Isolation and activity. Am. J. Public Health 1954, 44, 1326–1333. [Google Scholar] [CrossRef] [PubMed]
- McNerney, R.; Kambashi, B.S.; Kinkese, J.; Tembwe, R.; Godfrey-Faussett, P. Development of a bacteriophage phage replication assay for diagnosis of pulmonary tuberculosis. J. Clin. Microbiol. 2004, 42, 2115–2120. [Google Scholar] [CrossRef] [PubMed]
- Rees, C.; Botsaris, G. The use of phage for detection, antibiotic sensitivity testing and enumeration. In Understanding Tuberculosis—Global Experiences and Innovative Approaches to the Diagnosis; Cardona, P.-J., Ed.; IntechOpen: London, UK, 2012; pp. 293–306. [Google Scholar]
- Hatfull, G.F. Molecular genetics of mycobacteriophages. Microbiol. Spectr. 2014, 2, 1–36. [Google Scholar] [CrossRef] [PubMed]
- Lazraq, R.; Moniz-Pereira, J.; Clavel-Seres, S.; Clement, F.; David, H.L. Restriction map of mycobacteriophage D29 and its deletion mutant F5. Acta Leprol. 1989, 7, 234–238. [Google Scholar]
- Ford, M.E.; Sarkis, G.J.; Belanger, A.E.; Hendrix, R.W.; Hatfull, G.F. Genome structure of mycobacteriophage D29: Implications for phage evolution. J. Mol. Biol. 1998, 279, 143–164. [Google Scholar] [CrossRef]
- Rybniker, J.; Kramme, S.; Small, P.L. Host range of 14 mycobacteriophages in Mycobacterium ulcerans and seven other mycobacteria including Mycobacterium tuberculosis—Application for identification and susceptibility testing. J. Med. Microbiol. 2006, 55, 37–42. [Google Scholar] [CrossRef]
- Foddai, A.C.G.; Grant, I.R. Sensitive and specific detection of viable Mycobacterium avium subsp. paratuberculosis in raw milk by the peptide-mediated magnetic separation-phage assay. J. Appl. Microbiol. 2017, 122, 1357–1367. [Google Scholar] [CrossRef]
- Albert, H.; Heydenrych, A.; Mole, R.; Trollip, A.; Blumberg, L. Evaluation of FASTPlaqueTB-RIF™, a rapid, manual test for the determination of rifampicin resistance from Mycobacterium tuberculosis cultures. Int. J. Tuberc. Lung Dis. 2001, 5, 906–911. [Google Scholar] [PubMed]
- Chauca, J.A.; Palomino, J.C.; Guerra, H. Evaluation of rifampicin and isoniazid susceptibility testing of Mycobacterium tuberculosis by a mycobacteriophage D29-based assay. J. Med. Microbiol. 2007, 56, 360–364. [Google Scholar] [CrossRef] [PubMed]
- Stanley, E.C.; Mole, R.J.; Smith, R.J.; Glenn, S.M.; Barer, M.R.; McGowan, M.; Rees, C.E.D. Development of a new, combined rapid method using phage and PCR for detection and identification of viable Mycobacterium paratuberculosis bacteria within 48 hours. Appl. Environ. Microb. 2007, 73, 1851–1857. [Google Scholar] [CrossRef] [PubMed]
- Grant, I.R.; Foddai, A.C.G.; Tarrant, J.C.; Kunkel, B.; Hartmann, F.A.; McGuirk, S.; Hansen, C.; Talaat, A.M.; Collins, M.T. Viable Mycobacterium avium ssp. paratuberculosis isolated from calf milk replacer. J. Dairy Sci. 2017, 100, 9723–9735. [Google Scholar] [CrossRef] [PubMed]
- Botsaris, G.; Liapi, M.; Kakogiannis, C.; Dodd, C.E.R.; Rees, C.E.D. Detection of Mycobacterium avium subsp. paratuberculosis in bulk tank milk by combined phage-PCR assay: Evidence that plaque number is a good predictor of MAP. Int. J. Food Microbiol. 2013, 164, 76–80. [Google Scholar] [CrossRef]
- Swift, B.M.C.; Convery, T.W.; Rees, C.E.D. Evidence of Mycobacterium tuberculosis complex bacteraemia in intradermal skin test positive cattle detected using phage-RPA. Virulence 2016, 7, 779–788. [Google Scholar] [CrossRef]
- Samaddar, S.; Grewal, R.K.; Sinha, S.; Ghosh, S.; Roy, S.; Das Gupta, S.K. Dynamics of mycobacteriophage-mycobacterial host interaction: Evidence for secondary mechanisms for host lethality. Appl. Environ. Microbiol. 2016, 82, 124–133. [Google Scholar] [CrossRef]
- Swift, B.M.C.; Meade, N.; Barron, E.S.; Bennett, M.; Perehenic, T.; Hughes, V.; Stevenson, K.; Rees, C.E.D. The development and use of Actiphage to detect viable mycobacteria from bovine tuberculosis and Johne’s disease-infected animals. Microb. Biotechnol. 2020, 13, 738–746. [Google Scholar] [CrossRef]
- Shenai, S.; Rodrigues, C.; Mehta, A.P. Evaluation of a new phage amplification technology for rapid diagnosis of tuberculosis. Indian J. Med. Microbiol. 2002, 20, 194–199. [Google Scholar]
- Verma, R.; Swift, B.; Handley-Hartill, W.; Lee, J.; Woltmann, G.; Rees, C.; Haldar, P. A novel high sensitivity bacteriophage-based assay identifies low level M. tuberculosis bacteriaemia in immunocompetent patients with active and incipient TB. Clin. Infect. Dis. 2019, 70, 933–936. [Google Scholar]
- Mbulo, G.M.; Kambashi, B.S.; Kinkese, J.; Tembwe, R.; Shumba, B.; Godfrey-Faussett, P.; McNerney, R. Comparison of two bacteriophage tests and nucleic acid amplification for the diagnosis of pulmonary tuberculosis in sub-saharan Africa. Int. J. Tuberc. Lung Dis. 2004, 8, 1342–1347. [Google Scholar] [PubMed]
- Park, D.J.; Drobniewski, F.A.; Meyer, A.; Wilson, S.M. Use of a phage-based assay for phenotypic detection of mycobacteria directly from sputum. J. Clin. Microbiol. 2003, 41, 680–688. [Google Scholar] [CrossRef] [PubMed]
- Cavusoglu, C.; Guneri, S.; Suntur, M.; Bilgic, A. Clinical evaluation of the FASTPlaqueTB for the rapid diagnosis of pulmonary tuberculosis. Turk. J. Med. Sci 2002, 32, 487–492. [Google Scholar]
- Albay, A.; Kisa, O.; Baylan, O.; Doganci, L. The evaluation of FASTPlaqueTB™ test for the rapid diagnosis of tuberculosis. Diagn. Microbiol. Infec. Dis. 2003, 46, 211–215. [Google Scholar] [CrossRef]
- Butt, T.; Ahmad, R.N.; Kazmi, S.Y.; Mahmood, A. Rapid diagnosis of pulmonary tuberculosis by mycobacteriophage assay. Int. J. Tuberc. Lung Dis. 2004, 8, 899–902. [Google Scholar]
- Biswas, D.; Deb, A.; Gupta, P.; Prasad, R.; Negi, K.S. Evaluation of the usefulness of phage amplification technology in the diagnosis of patients with paucibacillary tuberculosis. Indian J. Med. Microbiol. 2008, 26, 75–78. [Google Scholar] [CrossRef][Green Version]
- Singh, S.; Saluja, T.P.; Kaur, M.; Khilnani, G.C. Comparative evaluation of FASTPlaque assay with PCR and other conventional In Vitro diagnostic methods for the early detection of pulmonary tuberculosis. J. Clin. Lab. Anal. 2008, 22, 367–374. [Google Scholar] [CrossRef]
- Trollip, A.P.; Albert, H.; Mole, R.; Marshall, T.; van Cutsem, G.; Coetzee, D. Performance of FASTPlaqueTB™ and a modified protocol in a high HIV prevalence community in South Africa. Int. J. Tuberc. Lung Dis. 2009, 13, 791–793. [Google Scholar]
- Bellen, A.L.; Ang, C.F.; Montoya, J.C.; Mendoza, M.T. Accuracy of a bacteriophage-based assay in the rapid diagnosis of pulmonary tuberculosis. J. Microbiol. Infect. Dis. 2003, 32, 1–10. [Google Scholar]
- Zhu, C.T.; Cui, Z.L.; Zheng, R.J.; Yang, H.; Jin, R.L.; Qin, L.H.; Liu, Z.H.; Wang, J.; Hu, Z.Y. A multi-center study to evaluate the performance of phage amplified biologically assay for detecting TB in sputum in the pulmonary TB patients. PLoS ONE 2011, 6, e24435. [Google Scholar] [CrossRef]
- Zhao, N.; Sun, J.Y.; Xu, H.P.; Sun, F.Y. Early diagnosis of tuberculosis-associated IgA nephropathy with ESAT-6. Tohoku J. Exp. Med. 2017, 241, 271–279. [Google Scholar] [CrossRef]
- Falkinham, J.O. Epidemiology of infection by nontuberculous mycobacteria. Clin. Microbiol Rev. 1996, 9, 177–215. [Google Scholar] [CrossRef] [PubMed]
- Takiff, H.; Heifets, L. In search of rapid diagnosis and drug-resistance detection tools: Is the FASTPlaqueTB test the answer? Int. J Tuberc. Lung Dis. 2002, 6, 560–561. [Google Scholar] [PubMed]
- Swift, B.M.C.; Gerrard, Z.E.; Huxley, J.N.; Rees, C.E.D. Factors affecting phage D29 infection: A tool to investigate different growth states of mycobacteria. PLoS ONE 2014, 9, e106690. [Google Scholar] [CrossRef] [PubMed]
- Foddai, A.; Elliott, C.T.; Grant, I.R. Optimization of a phage amplification assay to permit accurate enumeration of viable Mycobacterium avium subsp. paratuberculosis cells. Appl. Environ. Microb. 2009, 75, 3896–3902. [Google Scholar] [CrossRef]
- Botsaris, G.; Slana, I.; Liapi, M.; Dodd, C.; Economides, C.; Rees, C.; Pavlik, I. Rapid detection methods for viable Mycobacterium avium subspecies paratuberculosis in milk and cheese. Int. J. Food Microbiol. 2010, 141, S87–S90. [Google Scholar] [CrossRef]
- Botsaris, G.; Swift, B.M.C.; Slana, I.; Liapi, M.; Christodoulou, M.; Hatzitofi, M.; Christodoulou, V.; Rees, C.E.D. Detection of viable Mycobacterium avium subspecies paratuberculosis in powdered infant formula by phage-PCR and confirmed by culture. Int. J. Food Microbiol. 2016, 216, 91–94. [Google Scholar] [CrossRef]
- Gerrard, Z.E.; Swift, B.M.C.; Botsaris, G.; Davidson, R.S.; Hutchings, M.R.; Huxley, J.N.; Rees, C.E.D. Survival of Mycobacterium avium subspecies paratuberculosis in retail pasteurised milk. Food Microbiol. 2018, 74, 57–63. [Google Scholar] [CrossRef]
- Altic, L.C.; Rowe, M.T.; Grant, I.R. UV light inactivation of Mycobacterium avium subsp. paratuberculosis in milk as assessed by FASTPlaqueTB phage assay and culture. Appl. Environ. Microb. 2007, 73, 3728–3733. [Google Scholar] [CrossRef]
- Donaghy, J.; Keyser, M.; Johnston, J.; Cilliers, F.P.; Gouws, P.A.; Rowe, M.T. Inactivation of Mycobacterium avium ssp. paratuberculosis in milk by UV treatment. Lett. Appl. Microbiol. 2009, 49, 217–221. [Google Scholar] [CrossRef] [PubMed]
- Akineden, O.; Weirich, S.; Abdulmawjood, A.; Failing, K.; Bulte, M. Application of a fluorescence microscopy technique for detecting viable Mycobacterium avium ssp. paratuberculosis cells in milk. Food Anal. Method 2015, 8, 499–506. [Google Scholar] [CrossRef]
- Foddai, A.; Elliott, C.T.; Grant, I.R. Rapid assessment of the viability of Mycobacterium avium subsp. paratuberculosis cells after heat treatment, using an optimized phage amplification assay. Appl. Environ. Microb. 2010, 76, 1777–1782. [Google Scholar] [CrossRef]
- Swift, B.M.C.; Denton, E.J.; Mahendran, S.A.; Huxley, J.N.; Rees, C.E.D. Development of a rapid phage-based method for the detection of viable Mycobacterium avium subsp. paratuberculosis in blood within 48 h. J. Microbiol. Meth. 2013, 94, 175–179. [Google Scholar] [CrossRef]
- Boyle, D.S.; Lehman, D.A.; Lillis, L.; Peterson, D.; Singhal, M.; Armes, N.; Parker, M.; Piepenburg, O.; Overbaugh, J. Rapid detection of HIV-1 proviral DNA for early infant diagnosis using recombinase polymerase amplification. Mbio 2013, 4, e00135–e00213. [Google Scholar] [CrossRef]
- Slana, I.; Liapi, M.; Moravkova, M.; Kralova, A.; Pavlik, I. Mycobacterium avium subsp. paratuberculosis in cow bulk tank milk in Cyprus detected by culture and quantitative IS900 and F57 real-time PCR. Prev. Vet. Med. 2009, 89, 223–226. [Google Scholar] [CrossRef]
- Bradner, L.; Robbe-Austerman, S.; Beitz, D.C.; Stabel, J.R. Optimization of hexadecylpyridinium chloride decontamination for culture of Mycobacterium avium subsp. paratuberculosis from milk. J. Clin. Microbiol. 2013, 51, 1575–1577. [Google Scholar] [CrossRef]
- Slana, I.; Paolicchi, F.; Janstova, B.; Navratilova, P.; Pavlik, I. Detection methods for Mycobacterium avium subsp. paratuberculosis in milk and milk products: A review. Vet. Med. Czech. 2008, 53, 283–306. [Google Scholar] [CrossRef]
- Atreya, R.; Bulte, M.; Gerlach, G.F.; Goethe, R.; Hornef, M.W.; Kohler, H.; Meens, J.; Mobius, P.; Roeb, E.; Weiss, S.; et al. Facts, myths and hypotheses on the zoonotic nature of Mycobacterium avium subspecies paratuberculosis. Int. J. Med. Microbiol. 2014, 304, 858–867. [Google Scholar] [CrossRef]
- Millar, D.; Ford, J.; Sanderson, J.; Withey, S.; Tizard, M.; Doran, T.; Hermon-Taylor, J. IS900 PCR to detect Mycobacterium paratuberculosis in retail supplies of whole pasteurized cows’ milk in England and Wales. Appl. Environ. Microbiol. 1996, 62, 3446–3452. [Google Scholar] [CrossRef]
- Ayele, W.Y.; Svastova, P.; Roubal, P.; Bartos, M.; Pavlik, I. Mycobacterium avium subspecies paratuberculosis cultured from locally and commercially pasteurized cow’s milk in the Czech Republic. Appl. Environ. Microb. 2005, 71, 1210–1214. [Google Scholar] [CrossRef]
- Dundee, L.; Grant, I.R.; Ball, H.J.; Rowe, M.T. Comparative evaluation of four decontamination protocols for the isolation of Mycobacterium avium subsp. paratuberculosis from milk. Lett. Appl. Microbiol. 2001, 33, 173–177. [Google Scholar] [CrossRef]
- Gao, A.; Mutharia, L.; Raymond, M.; Odumeru, J. Improved template DNA preparation procedure for detection of Mycobacterium avium subsp. paratuberculosis in milk by PCR. J. Microbiol. Meth. 2007, 69, 417–420. [Google Scholar] [CrossRef]
- Hruska, K.; Slana, I.; Kralik, P.; Pavlik, I. Mycobacterium avium subsp. paratuberculosis in powdered infant milk: F57 competitive real time PCR. Vet. Med. Czech. 2011, 56, 226–230. [Google Scholar] [CrossRef]
- Maggioli, M.F. A bloody evidence: Is Mycobacterium bovis bacteraemia frequent in cattle?! Virulence 2016, 7, 748–750. [Google Scholar] [CrossRef]
- Haas, C.; Potaufeux, V.; Caplain, C.; Dangien, C.; Meunier, A.; Sellal, E.; Pelletier, C.; Rees, C.; Swift, B. Detection of active infection of new-born calves by Mycobacterium avium subsp. paratuberculosis (MAP) in first days of life. In Proceedings of the 5th Congress of the European Association of Veterinary Laboratory Diagnosticians, Brussels, Belgium, 14–17 October 2018. [Google Scholar]
- Karch, H.; JanetzkiMittmann, C.; Aleksic, S.; Datz, M. Isolation of enterohemorrhagic Escherichia coli O157 strains from patients with hemolytic-uremic syndrome by using immunomagnetic separation, DNA-based methods, and direct culture. J. Clin. Microbiol. 1996, 34, 516–519. [Google Scholar] [CrossRef]
- Rijpens, N.; Herman, L.; Vereccken, F.; Jannes, G.; De Smedt, J.; De Zutter, L. Rapid detection of stressed Salmonella spp. in dairy and egg products using immunomagnetic separation and PCR. Int. J. Food Microbiol. 1999, 46, 37–44. [Google Scholar] [CrossRef]
- Foddai, A.; Elliott, C.T.; Grant, I.R. Maximizing capture efficiency and specificity of magnetic separation for Mycobacterium avium subsp. paratuberculosis cells. Appl. Environ. Microb. 2010, 76, 7550–7558. [Google Scholar] [CrossRef]
- Foddai, A.C.G.; Grant, I.R. An optimised milk testing protocol to ensure accurate enumeration of viable Mycobacterium avium subsp. paratuberculosis by the PMS-phage assay. Int. Dairy J. 2015, 51, 16–23. [Google Scholar] [CrossRef]
- Swift, B.M.C.; Huxley, J.N.; Plain, K.M.; Begg, D.J.; de Silva, K.; Purdie, A.C.; Whittington, R.J.; Rees, C.E.D. Evaluation of the limitations and methods to improve rapid phage-based detection of viable Mycobacterium avium subsp. paratuberculosis in the blood of experimentally infected cattle. BMC Vet. Res. 2016, 12, 1–8. [Google Scholar] [CrossRef] [PubMed]
- Butot, S.; Ricchi, M.; Sevilla, I.A.; Michot, L.; Molina, E.; Tello, M.; Russo, S.; Arrigoni, N.; Garrido, J.M.; Tomas, D. Estimation of performance characteristics of analytical methods for Mycobacterium avium subsp. paratuberculosis detection in dairy products. Front. Microbiol. 2019, 10, 509. [Google Scholar] [CrossRef]
- Stewart, L.D.; Foddai, A.; Elliott, C.T.; Grant, I.R. Development of a novel phage-mediated immunoassay for the rapid detection of viable Mycobacterium avium subsp. paratuberculosis. J. Appl. Microbiol. 2013, 115, 808–817. [Google Scholar] [CrossRef] [PubMed]
- Foddai, A.; Strain, S.; Whitlock, R.H.; Elliott, C.T.; Grant, I.R. Application of a peptide-mediated magnetic separation-phage assay for detection of viable Mycobacterium avium subsp. paratuberculosis to bovine bulk tank milk and feces samples. J. Clin. Microbiol. 2011, 49, 2017–2019. [Google Scholar] [CrossRef] [PubMed][Green Version]
- O’Brien, L.M.; McAloon, C.G.; Stewart, L.D.; Strain, S.A.J.; Grant, I.R. Diagnostic potential of the peptide-mediated magnetic separation (PMS)-phage assay and PMS-culture to detect Mycobacterium avium subsp. paratuberculosis in bovine milk samples. Transbound. Emerg. Dis. 2018, 65, 719–726. [Google Scholar] [CrossRef]

| PA | Bacterial Target | Matrix | Results | Reference |
|---|---|---|---|---|
| In-house | M. smegmatis (2 strains), M. avium, M. bovis BCG, M. tuberculosis | Middlebrook 7H9, LB broth, PBS | At 37 °C, the release of new generation of phages occurred 120 min after infection of M. smegmatis. FAS concentration of 10 mM was selected for routine use. D29 phages were able to detect less than 10 CFU of M. smegmatis. | [35] |
| M. tuberculosis | Smear-negative sputum and Middlebrook 7H9 | Inhibitory factor of sputum was identified and sample processing method before PA was suggested for its removal. Microcentrifuge-based approach with thixotropic silica was developed. Sodium citrate with calcium chloride offered greater protection (against the virucide) than OADC. Infection time of 1 to 3 h prior to FAS addition was optimal. A liquid culture end-point detection of progeny phages with MTT (colour indicator of viability) was tested—capable of detecting 60 viable MT in 1 mL of sputum. | [55] | |
| M. smegmatis, M. bovis BCG M. tuberculosis (14 isolates) | Middlebrook 7H9 | To achieve maximum infection rates, inoculation with D29 should not exceed 108 PFU/mL. The length of latent period varies in 13 M. tuberculosis isolates. One strain did not support infection by D29. LOD of M. bovis BCG was not improved by delaying plating until lysis. Fewer than 10 CFU were detected by PA and samples containing 100 CFU/mL were consistently found to be positive. | [37] | |
| M. ulcerans (18 strains), MT complex (7 strains), M. avium (3 strains), M. scrofulaceum (2 strains), M. marinum (2 strains), M. fortuitum, M. chelonae, M. smegmatis | Middlebrook 7H9 1 | Mycobacteriophages D29, L5, Bxz2 and TM4 have the broadest host range. Protocols of PA successfully adapted to M. ulcerans. The growth of M. ulcerans as well as the phage replication in this host is strongly restricted to temperatures below 35 °C, which can be used for differentiation between M. ulcerans and M. tuberculosis. | [42] |
| PA | Matrix (n) | Cont. + | TB Treatment | Sensitivity ° (%) | Specificity ° (%) | PPV ° (%) | NPV ° (%) | Other Methods Used | Country | Reference |
|---|---|---|---|---|---|---|---|---|---|---|
| FPTB | Sputum (1692) | 74 | NO | 75.2 (70.3) | 98.7 (99.0) | 89 (92) | 96 (95) | Smear microscopy, culture | South Africa | [12] |
| Sputum (80) | - | * | (27) | (97) | (90) | (55) | Smear microscopy, culture, AMTD | Turkey | [56] | |
| Sputum (584) | 70 | n. r. | 81.6 | 97.7 | 97 | 85 | Smear microscopy, culture | Pakistan | [13] | |
| Respiratory specimens (sputum, BAL, endotracheal secretion; 50) | - | Various | 93.1 /90.6/ (85.3) | 88.2 /100/ (100) | 93.1 /100/ (100) | 88.2 /76.9/ (76.2) | Culture, TB BACTEC culture | India | [52] | |
| Non-respiratory specimens (pleural fluid, CSF, cold abscess, lymph node, pus, urine; 40) | - | Various | 87.5 /90.9/ (59.5) | 93.8 /88.8/ (100) | 95.5 /90.9/ (100) | 83.3 /88.8/ (16.7) | ||||
| Sputum (201) | 9 | NO | /87.5/ | /96.9/ | /93.3/ | /93.9/ | Smear microscopy, culture, TB BACTEC culture, IS6110 PCR | Turkey | [57] | |
| Sputum (42) | 2 | NO | 64 | 93 | n. r. | n. r. | Smear microscopy, culture, IS6110 PCR | Egypt | [14] | |
| Urine (22) | - | NO | 100 | 100 | n. r. | n. r. | ||||
| Sputum (169) | 9 | NO | 77 | 96 | 92 | 87 | Smear microscopy, TB BACTEC culture | Pakistan | [58] | |
| Sputum (193) | 78 | n. r. | 20.7 | 90.7 | 42.8 | 77.2 | Smear microscopy, culture | Zambia | [54] | |
| Sputum (69) | 4 | n. r. | 32 | 77.5 | 32 | 64.6 | Smear microscopy, culture, AMTD | |||
| Respiratory specimens (sputum, BAL; 94) 1 | - | Various | 93.8 | 83.3 | 93.8 | 83.3 | Smear microscopy, culture, TB BACTEC culture, AMTD | India | [11] | |
| Non-respiratory specimens (pleural fluid, urine, tissue, CSF; 45) 1 | - | Various | 95.7 | 82.4 | 88 | 93.3 | ||||
| BAL and pleural biopsy (139) | - | NO | (58.8) | (97.9) | (98.1) | (56.5) | Smear microscopy, culture, histopathological examination | India | [59] | |
| Sputum (200) | - | NO | {76.7} | {86} | n. r. | n. r. | Smear microscopy, culture, BACTEC-MGIT-culture, ESAT-6; 16-23SrRNA PCR | India | [60] | |
| Smear-negative sputum (208) | 101 | NO | 31.2 | 94.9 | 50 | 88 | Culture | Kenya | [7] | |
| Sputum (68) | - | Various | 90.7 | 96 | 97.5 | 85.7 | Smear microscopy, culture | India | [8] | |
| Sputum (196) | - | * | 44.3 | 95.8 | 87 | 73 | Smear microscopy, culture | South Africa | [61] | |
| FPTB modified | Sputum (196) | - | * | 56.7 | 81.1 | 68 | 73 | |||
| PhageTek MB | Respiratory specimens (sputum, bronchial, transthoracic or tracheal aspirate, BAL; 2048) | - | Various | |58.3| | |99.1| | |83.2| | |96.9| | Smear microscopy, culture, BacT/ALERT 3D culture | Spain | [5] |
| Sputum (206) | 2 | † | 31 | 86 | 70 | 55 | Smear microscopy, culture | Philippines | [62] | |
| In-house | Sputum (513) | 17 | n. r. | 44.1 | 92.4 | 82.2 | 67.5 | Smear microscopy, culture | Zambia | [37] |
| Sputum (115) | 5 | n. r. | 45.3 | 94.7 | 88.9 | 65.1 | Smear microscopy, culture, AMTD | Zambia | [54] | |
| Sputum (1660) | - | n. r. | 98.4 (54.8) | 71.6 (99) | 67.7 (99.6) | 98.7 (33.4) | Smear microscopy, culture | China | [63] | |
| Urine (92) ” | - | n. r. | n. r. | n. r. | n. r. | n. r. | Culture, ELISA, HE staining, immunohistochemistry, immunofluorescence staining | China | [64] | |
| Actiphage | Blood (66) | - | NO | (73.3) | (94–100) | n. r. | n. r. | Smear microscopy, culture, nested PCR, QFT | UK | [53] |
| PA | Bacterial Target | Matrix (n) | Sample Volume (mL or g) | PA +ve (%)° | Culture +ve (%) | IS900 qPCR +ve (%) | Sample Origin | Reference |
|---|---|---|---|---|---|---|---|---|
| FPTB | MAP | Cattle milk (15) | 25 | 67 | - | - | n. r. | [46] |
| MAP | Cattle BTM (220) Cattle BTM (225) Sheep BTM (5) Goat BTM (13) Mixed sheep and goat BTM (19) Cheese (28) 1 | 30 30 30 30 30 5/50/15 | - 22.2 - - - 0 | - 0.9 * 0 0 0 0 | 28.6 - 20.0 0 5.3 25.0 | Cyprus | [69] | |
| MAP | Cattle BTM (225) | 50/30 | 22.2 | 0.9 * | - | Cyprus | [48] | |
| MAP | PIF (32) | 1 | 12.5 | 9.4 * | 21.9 | Cyprus | [70] | |
| In-house | M. bovis | SCCIT-positive cattle blood (41) SCCIT-negative cattle blood (45) | 2 2 | 66 0 | - - | - - | UK | [49] |
| MAP | Semi skimmed pasteurized milk (368) | 50 | 10.3 | - | - | UK | [71] | |
| Actiphage | M. bovis | SCCIT-positive cattle blood (41) SCCIT-negative cattle blood (45) | 2 2 | 95 0 | - - | - - | UK | [51] |
| MAP | Experimentally infected cattle blood (15) PTB-negative cattle blood (8) | 2 2 | 87 25 | 93.3 ” 0 ” | - - | UK | [51] |
| PA | Bacterial Target | Matrix | Results | Reference |
|---|---|---|---|---|
| FPTB | MAP (3 strains) | Middlebrook 7H9, UHT whole and semi skimmed milk | In culture medium, MAP kill rate of 2.6–3.3 log10 per 1000 mJ/mL UV dose was achieved by UV machine. In whole or semi skimmed milk, MAP kill rate of 0.5–1.0 log10 per 1000 mJ/mL UV dose was achieved. PFU counts were consistently 1–2 log10 lower than CFU counts. | [72] |
| MAP (4 strains), M. smegmatis, M. tuberculosis, M. bovis BCG | Medium FPTB | MAP must be viable to be detected by FPTB. 100% reproducibility, 100% specificity of plaque IS900 PCR was reached. PCR is not able to reliably amplify a single-copy genomic sequence from the progenitor cell in a plaque. Multiplex plaque PCR for detection M. bovis BCG, MT and MAP DNA was established. | [46] | |
| MAP (2 strains) | UHT whole milk | Significant difference in resistance to UV treatment between two MAP strains was recorded. Inactivation trend was similar for the culture and PA but culture gave consistently higher viable count (of approximately 0.5–2.0 log10 units). MAP kill rate of 0.1–0.6 log10 was achieved at 1000 mJ/mL regardless of strain used or method employed for MAP enumeration. | [73] | |
| MAP | Skim milk powder | PA was able to detect MAP in skim milk powder with a LOD of approximately 10 CFU/mL of reconstituted powder. | [70] | |
| FPTB modified | MAP (4 strains) | Medium FPTB, UHT whole and raw milk 1 | Cell counts by the fluorescence staining method were consistently 1–3 log10 lower than CFU/mL and PFU/mL. LOD for FPTB assay: spiked culture medium (6.2 × 100 PFU/mL), UHT milk (1.7 × 101 PFU/mL), raw milk (8.7 × 100 PFU/mL). | [74] |
| In-house | MAP (5 stains), M. smegmatis | Medium FPTB and Middlebrook 7H9, UHT whole milk | The mean burst times for M. smegmatis and four MAP strains were 63 and 222 min, respectively. Samples incubated in 2 mM CaCl2 overnight before phage addition showed the highest plaque count. The highest number of plaques was found in samples infected with D29 phage for 2 h and incubated for a further 90 min before plating. Plaques were recorded from culture medium and milk samples with less than 10 MAP CFU/mL. For spiked medium and milk, PFU/mL was consistently slightly higher (0.45 log10 and 0.23 log10, respectively) than CFU/mL. | [68] |
| MAP (4 strains) | UHT whole milk | High correlation between CFU/mL and PFU/mL counts obtained for samples before and after thermal stress was observed. PA was able to detect smaller numbers of MAP due to the larger sample volume tested (900 μL) than culture (100 μL). 5.2–6.6 log10 reduction in MAP numbers was achieved after heat treatment depending on temperature and time. | [75] | |
| MAP (3 strains), M. smegmatis | Middlebrook 7H9 2 | Phage D29 was not able to infect M. smegmatis and MAP cells grown under oxygen limiting conditions; on the contrary, phage TM4 could productively infect these cells. Phage D29 is able to infect the mycobacteria more efficiently than TM4 when cells are grown under aerobic conditions. D29 receptors are not altered or lost when mycobacteria are grown under oxygen limiting conditions. The recovery of the productive infectivity of D29, achieved when returning to an aerobic condition, requires de novo RNA synthesis. | [67] | |
| M. bovis BCG | Commercial sheep blood | LOD of approximately 10 cells/mL of blood was reached. Efficiency of uptake of M. bovis BCG cells by leukocytes of at least 50% was reached. PCR could not consistently detect IS6110 when only one or two M. bovis BCG plaques were present. RPA detected IS6110 and IS1081 from samples containing DNA extracted from 5 M. bovis BCG plaques, however only RPA IS6110 primers consistently amplified DNA when agar was extracted from one M. bovis BCG plaque mixed with 4 M. smegmatis plaques. | [49] | |
| Actiphage | M. smegmatis, M. bovis BCG, M. bovis, MAP (3 strains) | Middlebrook 7H9, commercial sheep blood | Incubation for 180 min should be sufficient to allow D29 to complete its replication cycle in M. smegmatis, M. bovis BCG and MAP. LOD of Actiphage is lower than that of original PA for MAP and clinical isolate of M. bovis in blood. LOD is the same for both Actiphage and original PA when detecting M. bovis BCG cells. | [51] |
| PA | PMS Type | Bacterial Target | Matrix | Results | Reference |
|---|---|---|---|---|---|
| In-house | Manual and automated | MAP (3 strains), Mycobacterium sp. 1 | Middlebrook 7H9, UHT whole milk | MyOne Tosylactivated Dynabeads coated with biotinylated aMp3 and aMptD peptides mixed 50:50 gave 91.5% capture efficiency. The optimized PMS-PA gave average 98.5% capture efficiency and a nonspecific recovery of 5.5%. LOD50 of the optimized PMS-PA was 1.9 PFU/mL of culture medium, 7.3 PFU/mL and 14.4 PFU/50 mL of UHT milk. Number of PFU recovered from spiked milk after automated PMS was 10-fold lower than that recovered from spiked culture medium. | [91] |
| Automated | MAP (4 strains) | Middlebrook 7H9, raw BTM 2, UHT whole milk | The milk pellet is the location of maximal numbers of MAP (>81.5% of initial inoculum) after centrifugation of a milk sample at 2500 g for 15 min at ambient temperature. Processing milk on the same day as collection or after overnight storage at 4 °C are the ideal conditions to maximize detection and achieve accurate enumeration of viable MAP cells. Samples can be frozen at −70 °C for up to one month without significant loss of MAP viability. Some evidence of inhibition was obtained for direct qPCR, but not for PMS-qPCR and PMS-PA. | [92] | |
| Manual | MAP (2 strains) | Middlebrook 7H9, commercial sheep blood | PMS step reduced sensitivity of PA (LOD = 7.3 × 102 PFU/mL of culture media), thus PA directly on isolated PBMC was superior to the PMS step. Detection of MAP directly by PA in PBMC was more reproducible than isolating MAP using PMS on whole blood samples. | [93] | |
| Automated | MAP (43 strains), Mycobacterium sp. 3, 5 bacterial isolates 4 | PBS-T20, UHT whole milk | 100% inclusivity of PMS-PA was achieved by testing 43 MAP strains. Of 12 Mycobacterium sp. only Mycobacterium bovis BCG produced small numbers of plaques. All five bacterial isolates tested negative by PMS-PA. LOD50 of the PMS-PA was 0.93 MAP PFU/50 mL UHT milk. PMS-PA proved to be more sensitive than PMS-qPCR and PMS- culture. | [43] | |
| Manual and automated | MAP (4 strains) | Raw bovine milk 5, milk 6, skim milk powder | Different sensitivity estimates were obtained for IS900 qPCR (94%), F57 qPCR (76%), culture (83%) and PMS-PA (40%) when comparing all matrices. LOD50 of PMS-PA was determined to be 3.7 log10 CFU/50 mL of both raw and heat-treated milk and 3.2 log10 CFU/50 mL of reconstituted milk powder. LOD95 of PMS-PA was determined to be 4.3 log10 CFU/50 mL of both raw and heat-treated milk and 3.8 log10 CFU/50 mL of reconstituted milk powder. | [94] | |
| PA-ELISA in-house | Manual and automated | MAP | Middlebrook 7H9, phosphate buffer, UHT milk, autoclaved bovine faeces | The dynamic range of the assay was found to be approx. 3 × 102–6 × 108 phage/mL. Analytical sensitivity of ELISA was almost identical in phosphate buffer, milk and feces samples. The estimation of MAP number in original specimen is possible by PMS-PA-ELISA. The largest burst size was recorded at high multiplicity of infection. OADC interfered with ELISA and had to be omitted. | [95] |
| FPTB | Manual | MAP (2 strains) | Commercial horse and sheep blood | Magnetic recovery of beads from blood was found to be inefficient; the centrifugation improved the capture. Horse blood—MAP detection by PMS-FPTB was not successful. Sheep blood—33% of MAP recovered by PMS-FPTB; 1 in 10 dilution of blood resulted in 92% MAP recovery. LOD of PMS-FPTB was determined to be 10 MAP/mL of sheep blood. | [71] |
| PA | PMS Type | Matrix (n) | Sample Volume (mL or g) | PMS-PA +ve (%)° | Culture +ve (%) ” | IS900 qPCR +ve (%) | Other Method Used | Sample Origin | Reference |
|---|---|---|---|---|---|---|---|---|---|
| In-house | n. r. | Fresh cattle BTM (25) Frozen cattle BTM (19) Frozen bovine faeces (39) | 50 50 1 | 40.0 21.1 51.3 | 12.0 * (10.5) * - | - - n. r. | - | UK USA USA | [96] |
| Manual | Experimentally infected cattle blood (19) | 1 | 36.8 | 10.5 † | 10.5 † | Serum ELISA | Australia | [93] | |
| JD-negative cattle blood (10) | 1 | 0 | 0† | 0 † | |||||
| Automated | Cattle individual milk (146) | 50 | 21.2 | (11.6) * | 9.1 +,# | PMS-F57 qPCR | UK | [43] | |
| Cattle BTM (22) | 50 | 59.1 | (50.0) * | 45.4 # | |||||
| Commercial CMR (83) | 1; 5–9 | 20.5 | 0; (14.5) * | 8.4 | - | USA | [47] | ||
| JD-infected cattle individual milk (40) | 50 | 32.5 | (25.0) * | - | Serum ELISA, faecal culture | UK | [97] | ||
| JD-free cattle individual milk (105) | 50 | 0 | (3.8) * | - | |||||
| FPTB | Manual | JD-infected cattle blood (9) JD-free cattle blood (5) JD-different status cattle blood (10) 1 | 1 1 1; 2 | 100.0 0 80.0 | - - (0) | - - - | Serum ELISA, milk ELISA | UK | [71] |
Publisher’s Note: MDPI stays neutral with regard to jurisdictional claims in published maps and institutional affiliations. |
© 2021 by the authors. Licensee MDPI, Basel, Switzerland. This article is an open access article distributed under the terms and conditions of the Creative Commons Attribution (CC BY) license (http://creativecommons.org/licenses/by/4.0/).
Share and Cite
Beinhauerova, M.; Slana, I. Phage Amplification Assay for Detection of Mycobacterial Infection: A Review. Microorganisms 2021, 9, 237. https://doi.org/10.3390/microorganisms9020237
Beinhauerova M, Slana I. Phage Amplification Assay for Detection of Mycobacterial Infection: A Review. Microorganisms. 2021; 9(2):237. https://doi.org/10.3390/microorganisms9020237
Chicago/Turabian StyleBeinhauerova, Monika, and Iva Slana. 2021. "Phage Amplification Assay for Detection of Mycobacterial Infection: A Review" Microorganisms 9, no. 2: 237. https://doi.org/10.3390/microorganisms9020237
APA StyleBeinhauerova, M., & Slana, I. (2021). Phage Amplification Assay for Detection of Mycobacterial Infection: A Review. Microorganisms, 9(2), 237. https://doi.org/10.3390/microorganisms9020237

